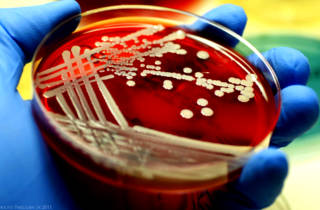

Особенности и опасность бактерий
Стафилококк — это грамположительные бактерии округлой формы, которые быстро размножаются. Эти микроорганизмы выделяют токсины, способные уничтожать клетки, а также фермент липазу. Липаза расщепляет жиры и разрушает сальные пробки в волосяных фолликулах, что приводит к образованию гнойничков на коже и слизистых оболочках.
Инфекция, вызванная стафилококками, чаще всего наблюдается у взрослых и детей в носовых проходах, подмышечных впадинах, а также в паховой области и во влагалище. Эти бактерии могут распространяться по всему организму, затрагивая различные ткани и органы, что приводит к общей интоксикации и может вызвать ряд серьезных заболеваний:
- хронические риниты и синуситы;
- атрофию слизистой оболочки;
- отит;
- сепсис;
- менингит;
- заболевания желудочно-кишечного тракта (при попадании со слизью в желудок);
- пневмонию;
- токсический шок.
Врачи отмечают, что лечение золотистого стафилококка в носу требует комплексного подхода. Основное внимание уделяется как местной, так и системной терапии. Специалисты рекомендуют использовать антисептические растворы для промывания носовых ходов, что помогает снизить количество патогенных микроорганизмов. В некоторых случаях назначаются антибиотики, однако их выбор должен основываться на результатах бактериологического посева, чтобы избежать развития резистентности.
Кроме того, врачи подчеркивают важность укрепления иммунной системы пациента. Это может включать в себя прием витаминов, адаптогенов и соблюдение режима дня. Также необходимо учитывать наличие сопутствующих заболеваний, таких как аллергический ринит или хронический синусит, которые могут усугублять течение инфекции. В целом, успешное лечение золотистого стафилококка требует индивидуального подхода и тщательного наблюдения за состоянием пациента.

Проблематика
В настоящее время лечение золотистого стафилококка представляет серьезную задачу, так как этот микроорганизм обладает высокой устойчивостью к большинству антибиотиков. Бактерии не поддаются иммунному ответу, поскольку активируются при снижении защитных функций организма, и антитела не могут справиться с инфекцией. Патогенные микроорганизмы отличаются живучестью и не погибают в следующих условиях:
- при высушивании;
- остаются активными более 12 часов под воздействием ультрафиолетового света;
- сохраняют жизнеспособность при температуре 150 °C более 10 минут;
- не уничтожаются в чистом этиловом спирте в течение около 10 минут;
- не реагируют на перекись водорода, так как вырабатывают фермент каталазу, который освобождает кислород из перекиси, усваиваемый стафилококком;
- могут существовать в соленой среде, что позволяет им находиться в человеческом поте.
Когда золотистый стафилококк появляется в носу, лечение становится сложным, так как бактерии быстро адаптируются к различным препаратам и развивают к ним устойчивость.
Микроорганизмы проявляют резистентность к антибиотикам пенициллиновой группы. Однако, когда этот природный компонент заменяют на химический аналог — мециллин, ситуация повторяется: при длительном применении препаратов на его основе патогенная микрофлора начинает вырабатывать устойчивость. Аналогичные процессы наблюдаются и при использовании средств на основе ванкомицина и гликопептидов.
| Метод лечения | Описание метода | Преимущества/Недостатки |
|---|---|---|
| Топические антибиотики (мази, спреи) | Нанесение антибактериальных препаратов непосредственно в носовые ходы. | Простота применения, местное воздействие, снижение риска системных побочных эффектов. Однако, может быть недостаточно эффективен при обширном поражении. |
| Системные антибиотики (таблетки, инъекции) | Прием антибиотиков внутрь или внутривенное введение. | Эффективен при обширном поражении, достигает высоких концентраций в крови и тканях. Однако, риск развития системных побочных эффектов, возможность развития резистентности. Выбор антибиотика должен основываться на результатах антибиотикограммы. |
| Бактериофаги | Использование вирусов, которые специфически поражают стафилококки. | Альтернативный метод лечения, меньший риск развития резистентности по сравнению с антибиотиками. Однако, эффективность может быть ниже, чем у антибиотиков, необходимы дальнейшие исследования. |
| Иммуномодуляторы | Препараты, стимулирующие иммунную систему для борьбы с инфекцией. | Может помочь организму самостоятельно справиться с инфекцией, снижает риск рецидивов. Однако, эффективность может быть ограничена, не всегда показано. |
| Санация носовой полости | Промывание носа растворами соли, использование антисептиков. | Помогает удалить бактерии и улучшить местный иммунитет. Должно применяться в комплексе с другими методами лечения. |
Тонкости выбора терапии
Выбор метода лечения бактериальной инфекции должен осуществляться только врачом. Заболевания, такие как стафилококковый отит и ринит, требуют внимательного подхода, поскольку микроорганизмы часто устойчивы к антибиотикам. Для определения реакции на конкретные препараты специалист проводит тесты. Правильный выбор терапии критически важен, так как неудачное лечение может привести к серьезным последствиям для здоровья пациента.
Если не провести тестирование на реакцию стафилококка, использование неверной схемы лечения может способствовать возникновению сверхрезистентных штаммов. Это также может произойти из-за частого и необоснованного применения мощных антибактериальных средств.
Препараты, которые не уничтожают бактерии, могут усугубить проблему, позволяя инфекции распространяться через кровеносную систему и вызывать серьезные осложнения. Прежде чем начать лечение, необходимо убедиться, что патогенные микроорганизмы адекватно реагируют на выбранные лекарства.
Лечение золотистого стафилококка в носу вызывает много обсуждений среди пациентов и врачей. Многие отмечают, что этот микроорганизм может вызывать различные заболевания, от простого насморка до более серьезных инфекций. Важно понимать, что самолечение может привести к осложнениям, поэтому консультация с врачом является необходимостью.
Некоторые пациенты делятся опытом применения антибиотиков, однако многие врачи подчеркивают, что не всегда это оправдано, так как стафилококк может быть устойчив к определенным препаратам. Альтернативные методы, такие как промывание носа солевыми растворами и использование пробиотиков, также находят своих сторонников.
Кроме того, важным аспектом является укрепление иммунной системы, что помогает организму справляться с инфекцией. В целом, подход к лечению должен быть индивидуальным и комплексным, учитывающим особенности каждого пациента.

Лечение заболевания
После тщательной диагностики и необходимых анализов врач назначает лечение золотистого стафилококка. Комплексная терапия включает антибактериальные средства местного и системного действия, а также антисептики для наружной обработки носа и иммуностимуляторы. Рассмотрим подробнее медикаменты, которые могут оказать положительное воздействие.
Средства местного воздействия
Препараты для лечения могут быть представлены в виде капель или мазей. Они разработаны для борьбы с бактериями, подавляя их активность или уничтожая. Вот некоторые из таких средств:
- Мазь «Бактробан». Этот препарат эффективен против стафилококков, устойчивых к метициллинсодержащим антибиотикам. Наносить мазь следует на внутреннюю поверхность ноздрей, избегая глубокого введения, дважды в день.
- Спрей «Биопарокс». Это мощный антибиотик местного действия, который можно использовать даже беременным женщинам. В комплекте идет специальная насадка для введения средства в носовую полость. Микрочастицы препарата проникают глубоко в носовые ходы и околоносовые пазухи, что позволяет обработать практически всю пораженную область за одно применение. Спрей не только уничтожает бактерии, но и уменьшает воспаление, что значительно облегчает состояние пациента в кратчайшие сроки.

Системные антибиотики
Препараты системного действия принимаются перорально или внутримышечно, а курс лечения обычно длительный. Схему лечения, продолжительность курса и другие аспекты определяет только врач. Передозировка этими медикаментами может серьезно угрожать здоровью, поэтому важно строго следовать указаниям специалиста. К эффективным средствам против золотистого стафилококка относятся «Уназин», «Оксациллин», «Цефтриаксон», «Амоксиклав» и другие.
Антисептики
Обработка носовой полости антисептическими средствами необходима для предотвращения размножения стафилококков. Для этой цели применяются специальные препараты, с которыми мы познакомимся подробнее.
| Препарат | Механизм действия | Особенности использования |
|---|---|---|
| «Хлорофиллипт» | Уничтожает некоторые штаммы бактерий и способствует заживлению повреждений на слизистой. | Из таблеток или масла готовят компрессы, турунды смачивают в растворе и помещают в носовые проходы. |
| «Зелень бриллиантовая» | Эффективна против стафилококков, которые погибают при контакте с ней. | Применяется только для обработки кожи вокруг носа, так как не предназначена для слизистых и может вызвать ожоги. |
| «Бактериофаги» | Вирусы-фаги уничтожают даже те штаммы стафилококков, которые не поддаются антибиотикам. | Жидкость с бактериофагами принимают внутрь, также из нее делают компрессы, смачивая турунды и помещая их в ноздри; курс лечения не должен превышать 10 дней. |
| «Перекись водорода» | Хотя неэффективна против стафилококков, хорошо дезинфицирует гнойные раны. | 3% раствор разводят кипяченой охлажденной водой в соотношении 1:11, чтобы избежать повреждения слизистой; применяют для компрессов или промываний. |
| Ихтиолка («Мазь Вишневского») | Способствует быстрому заживлению обработанных участков. | Наносится на слизистую или кожу. |
Иммуномодуляторы
Укрепление защитных механизмов организма — ключевая задача в лечении. Для повышения иммунитета можно использовать препараты, такие как «Тактивин» (пептидный иммуностимулятор), «Полиоксидоний» (синтетический иммуномодулятор), «Иммунал» и «ИРС-10» (капли для носа). Также пациентам рекомендуется принимать витаминно-минеральные комплексы. Как только иммунная система восстановит свою нормальную функцию, заболевание начнет ослабевать.
Лечение народными средствами
В некоторых случаях народные средства могут приносить положительные результаты. Однако важно помнить, что они не заменяют медикаментозное лечение, назначенное врачом. Также следует осторожно подходить к выбору рецептов, так как некоторые компоненты могут вызывать аллергические реакции.
Рассмотрим несколько методов лечения:
-
Петрушка и сельдерей. Вещества, содержащиеся в этих растениях, эффективно уничтожают бактерии. При хронических заболеваниях полезно употреблять сок из корней. Для его приготовления измельчите ингредиенты и отожмите сок: на одну часть сока сельдерея берите две части сока петрушки, смешайте и принимайте по одной чайной ложке за 40 минут до еды.
-
Настой для промывания. Для его приготовления используйте сушёный корень лопуха и окопника лекарственного. Возьмите по половине столовой ложки каждого ингредиента, тщательно измельчите, залейте стаканом кипящей воды и настаивайте полчаса. Охлаждённый настой процедите и используйте для промывания носа.
-
Отвар для внутреннего применения. Возьмите по две чайные ложки сушёных корней лопуха и эхинацеи, залейте четырьмя стаканами кипятка и варите на медленном огне в течение 20 минут. Процеженный отвар принимайте по полстакана три раза в день.
Осторожность в лечении
При лечении золотистого стафилококка важно тщательно выбирать медикаменты и народные средства. Антибиотики, хотя и эффективные, могут вызывать серьезные побочные эффекты. Особенно осторожно их назначают детям, беременным и пожилым людям с хроническими заболеваниями.
Лекарственные травы также имеют свои риски и не всегда безопасны. Дозировка народных средств для детей должна быть ниже, чем для взрослых.
Если у пациента есть аллергия на определенные вещества, необходимо пройти тест на аллергию перед началом лечения. Биологически активные компоненты могут усваиваться организмом в значительных количествах, что в некоторых случаях представляет опасность для здоровья.
Подведем итоги
Золотистый стафилококк обитает на коже и слизистых оболочках большинства людей и не представляет угрозы для здоровья, пока не начинает активно размножаться. Лечение может быть сложным, так как бактерии быстро развивают устойчивость к антибиотикам.
Тем не менее, комплексный подход к терапии, включающий подавление патогенных микроорганизмов и укрепление иммунной системы, может помочь решить эту проблему. Если вы заметили гнойнички на слизистой носа или вокруг него, обязательно проконсультируйтесь с врачом, чтобы избежать серьезных последствий.
Источники: medscape.com, health.harvard.edu, medicalnewstoday.com.
Вопрос-ответ
Каковы основные симптомы инфекции, вызванной золотистым стафилококком в носу?
Симптомы могут включать заложенность носа, выделения из носа (включая гнойные), зуд и раздражение слизистой оболочки, а также возможное образование корок. В некоторых случаях может наблюдаться повышение температуры и общее недомогание.
Какие методы диагностики используются для выявления золотистого стафилококка?
Для диагностики инфекции обычно проводят бактериологический посев из носа, который позволяет определить наличие золотистого стафилококка и его чувствительность к антибиотикам. Также могут использоваться методы ПЦР для более быстрой и точной диагностики.
Каковы основные подходы к лечению данной инфекции?
Лечение может включать применение местных антисептиков и антибиотиков, а также системных антибиотиков в более тяжелых случаях. Важно также соблюдать гигиену носа и, при необходимости, использовать противовоспалительные средства для уменьшения симптомов.
Советы
СОВЕТ №1
Обратитесь к врачу для точной диагностики. Лечение золотистого стафилококка требует профессионального подхода, поэтому важно получить консультацию от специалиста, который сможет назначить необходимые анализы и определить степень инфекции.
СОВЕТ №2
Следуйте предписаниям врача. Если вам назначены антибиотики или другие препараты, строго придерживайтесь схемы лечения и не прекращайте прием медикаментов без рекомендации врача, даже если симптомы исчезли.
СОВЕТ №3
Уделяйте внимание гигиене носа. Регулярное промывание носовых ходов солевыми растворами поможет удалить бактерии и снизить риск повторного заражения. Используйте только стерильные и безопасные средства для промывания.
СОВЕТ №4
Укрепляйте иммунную систему. Правильное питание, физическая активность и достаточный сон помогут вашему организму лучше справляться с инфекциями. Рассмотрите возможность приема витаминов и минералов, которые поддерживают иммунитет.